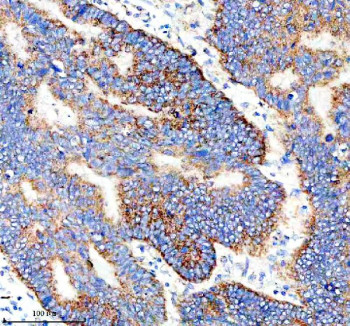
Anti-IER3 / Immediate early response gene 3

Cookie preferences
This website uses cookies, which are necessary for the technical operation of the website and are always set. Other cookies, which increase the comfort when using this website, are used for direct advertising or to facilitate interaction with other websites and social networks, are only set with your consent.
Configuration
Technically required
These cookies are necessary for the basic functions of the shop.
"Allow all cookies" cookie
"Decline all cookies" cookie
CSRF token
Cookie preferences
Currency change
Customer-specific caching
FACT-Finder tracking
Individual prices
Selected shop
Session
Comfort functions
These cookies are used to make the shopping experience even more appealing, for example for the recognition of the visitor.
Note
Show the facebook fanpage in the right blod sidebar
Statistics & Tracking
Affiliate program
Conversion and usertracking via Google Tag Manager
Track device being used
| Item number | Size | Datasheet | Manual | SDS | Delivery time | Quantity | Price |
|---|---|---|---|---|---|---|---|
| NSJ-FY12932 | 100 µg | - | - |
3 - 10 business days* |
790.00€
|
If you have any questions, please use our Contact Form.
You can also order by e-mail: info@biomol.com
Larger quantity required? Request bulk
You can also order by e-mail: info@biomol.com
Larger quantity required? Request bulk
Adding 0.2 ml of distilled water will yield a concentration of 500 ug/ml. IER3 antibody detects... more
Product information "Anti-IER3 / Immediate early response gene 3"
Adding 0.2 ml of distilled water will yield a concentration of 500 ug/ml. IER3 antibody detects Immediate early response gene 3 protein, a stress-inducible regulator of apoptosis and cell survival pathways. The UniProt recommended name is Immediate early response 3 (IER3), also known as IEX-1, DIF-2, gly96, and radiation-inducible protein. IER3 acts as a rapid responder to stress, mitogenic, and inflammatory signals, mediating downstream responses to NF-kappaB, p53, and MAPK pathways. Its expression is transiently induced by stimuli such as UV radiation, cytokines (TNF-alpha, IL-1), and growth factors, reflecting its role in adaptive cell signaling.Functionally, IER3 antibody targets a multifunctional protein that modulates apoptosis by interacting with BCL2 family members and regulating mitochondrial membrane potential. It can act as either pro- or anti-apoptotic depending on cell context and stimulus. IER3 has been implicated in cell cycle control, stress tolerance, and immune regulation, with overexpression protecting cells from TNF-induced apoptosis via suppression of caspase-3 activation. Conversely, downregulation promotes sensitivity to radiation and chemotherapeutic stress, linking IER3 to cancer therapy resistance mechanisms.IER3 localizes mainly to the cytoplasm but can also translocate to the nucleus in certain stress conditions. The IER3 antibody is valuable for monitoring expression patterns across tissues, including spleen, thymus, and epithelial cells, and in cancers such as leukemia, breast, and colon carcinoma. The IER3 gene is located on chromosome 6p21.33, close to the major histocompatibility complex (MHC) region, encoding a 156-amino acid protein. Its promoter contains NF-kappaB binding sites, allowing rapid induction following stress or infection. IER3 acts as a negative feedback regulator in immune responses, balancing cytokine signaling and cellular resilience.IER3 also regulates ERK and AKT phosphorylation states, controlling cellular energy metabolism and proliferation. Its modulation of mitochondrial ATP synthase interaction contributes to ROS balance. NSJ Bioreagents provides IER3 antibody reagents optimized for detecting both native and induced protein forms across species for use in multiple applications.Through its unique duality in regulating cell survival, IER3 remains a critical molecular switch in stress adaptation, immune tolerance, and oncogenesis.
| Keywords: | Anti-IER3, Anti-Immediate early protein GLY96, Anti-PACAP-responsive gene 1 protein, Anti-Immediate early response 3 protein, Anti-Differentiation-dependent gene 2 protein, Anti-Radiation-inducible immediate-early gene IEX-1, IER3 Antibody / Immediate ear |
| Supplier: | NSJ Bioreagents |
| Supplier-Nr: | FY12932 |
Properties
| Application: | WB, IHC, FC |
| Antibody Type: | Polyclonal |
| Conjugate: | No |
| Host: | Rabbit |
| Species reactivity: | human |
| Immunogen: | A synthetic peptide corresponding to a sequence at the C-terminus of human IER3 |
| Format: | Purified |
Database Information
| UniProt ID : | P46695 | Matching products |
| Gene ID : | GeneID 8870 | Matching products |
Handling & Safety
| Storage: | +4°C |
| Shipping: | +4°C (International: +4°C) |
Caution
Our products are for laboratory research use only: Not for administration to humans!
Our products are for laboratory research use only: Not for administration to humans!
Information about the product reference will follow.
more
You will get a certificate here
Viewed